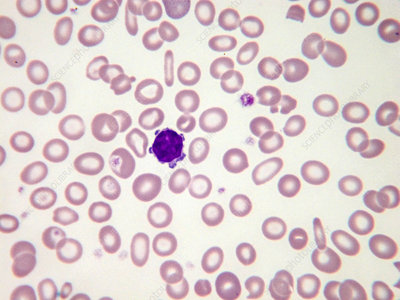
image

Multiple Myeloma: Understanding A Blood Cancer That Affects Bone Marrow
17 Dec, 2025
Dr. Rajesh Bollam

Multiple Myeloma: Understanding a Blood Cancer That Affects Bone Marrow
Multiple Myeloma is a type of blood cancer that begins in the bone marrow, the soft tissue inside bones where blood cells are produced. It affects plasma cells, an important part of the immune system and can weaken bones, reduce immunity, and impact overall health if not diagnosed early.
With advances in medical oncology, multiple myeloma is now highly manageable, especially when detected at the right time.
What Is Multiple Myeloma?
In multiple myeloma, abnormal plasma cells multiply uncontrollably in the bone marrow. These cancerous cells crowd out healthy blood cells and produce abnormal proteins that can damage bones, kidneys, and immunity.
It most commonly affects:
- Adults above 50 years
- Men slightly more than women
- People with long-standing immune or plasma cell disorders
Common Symptoms You Should Not Ignore
Multiple myeloma symptoms often develop gradually and may be mistaken for aging or routine health issues.
Key Warning Signs:
- Persistent bone pain, especially in the back, ribs, or hips
- Fatigue and weakness due to anemia
- Frequent infections caused by low immunity
- Unexplained fractures or bone thinning
- Weight loss and reduced appetite
If these symptoms persist, medical evaluation is essential.
How Is Multiple Myeloma Diagnosed?
Diagnosis usually involves a combination of tests, including:
- Blood tests to detect abnormal proteins
- Bone marrow biopsy
- Imaging studies (X-ray, MRI, PET-CT) to assess bone damage
- Kidney function and calcium level tests
Early diagnosis helps prevent complications and improves treatment outcomes.
Modern Treatment Options for Multiple Myeloma
Today, multiple myeloma treatment has advanced significantly, offering patients better survival and quality of life.
Treatment may include:
- Targeted therapy
- Immunotherapy
- Chemotherapy
- Steroids
- Bone marrow (stem cell) transplant in eligible patients
Treatment plans are personalized based on age, disease stage, and overall health.
Why Early Diagnosis Matters
- Better control of bone damage
- Reduced risk of kidney failure
- Improved response to modern therapies
- Longer disease-free survival
Regular follow-ups and timely treatment are key to managing multiple myeloma effectively.
Expert Care at Renova Hospitals
At Renova Hospitals, patients with multiple myeloma receive comprehensive care under the guidance of Dr. Rajesh Bollam, an experienced and European-certified Medical Oncologist.
Multiple myeloma is a serious condition, but with early diagnosis, modern treatments, and expert care, patients can live longer and better lives.
Book Your Consultation Today
Dr. Rajesh Bollam
Director – Renova Hospitals
www.drrajeshoncologist.com
+91 9505878232
Recent Posts

Multiple Myeloma: Understanding a Blood Cancer That Affects Bone Marrow
Dec 17, 2025
Dr. Rajesh Bollam

Bone Marrow Transplantation in children
Aug 27, 2024
Dr. Rajesh Bollam

All you need to know about Childhood Cancers
Aug 26, 2024
Dr. Rajesh Bollam

Signs of Liver Cancer
May 30, 2024
Dr. Rajesh Bollam

CAR T-cell therapy
Mar 01, 2024
Dr. Rajesh Bollam

Mediastinal tumors
Jun 03, 2022
Dr. Rajesh Bollam

Transfusion medicine for RBCs
Apr 18, 2022
Dr. Rajesh Bollam

Sickle Cell Anemia
Apr 15, 2022
Dr. Rajesh Bollam

What iss new in cancer immunotherapy?
Nov 30, 2021
Dr. Rajesh Bollam

What is immunotherapy?
Nov 30, 2021
Dr. Rajesh Bollam

What causes breast cancer?
Nov 30, 2021
Dr. Rajesh Bollam

Who gets breast cancer?
Nov 30, 2021
Dr. Rajesh Bollam

Breast cancer symptoms
Nov 30, 2021
Dr. Rajesh Bollam

Types of breast cancer
Nov 30, 2021
Dr. Rajesh Bollam

Types of invasive breast cancers
Nov 30, 2021
Dr. Rajesh Bollam

Breast cancer treatment plan
Nov 30, 2021
Dr. Rajesh Bollam

How to prevent cervical cancer
Nov 22, 2021
Dr. Rajesh Bollam

What is cervical cancer?
Nov 22, 2021
Dr. Rajesh Bollam

Are there tests for early detection?
Nov 22, 2021
Dr. Rajesh Bollam

Breast cancer risk factors
Nov 22, 2021
Dr. Rajesh Bollam

Staging and Treatment for oral cancer
Nov 22, 2021
Dr. Rajesh Bollam

How to prevent oral cancer
Nov 22, 2021
Dr. Rajesh Bollam

Risk factors of oral cancer
Nov 22, 2021
Dr. Rajesh Bollam

What is oral cancer?
Nov 22, 2021
Dr. Rajesh Bollam

The Lymph System of the Breast
Nov 22, 2021
Dr. Rajesh Bollam

What Is Breast Cancer?
Nov 22, 2021
Dr. Rajesh Bollam

Kidney Cancer: Myths & Reality
Nov 12, 2021
Dr. Rajesh Bollam

Bone marrow biopsy
Sep 29, 2021
Dr. Rajesh Bollam

Leukemia
May 28, 2021
Dr. Rajesh Bollam

Stomach Cancer
May 28, 2021
Dr. Rajesh Bollam

Blood Cancer : Types and Treatment
May 21, 2021
Dr. Rajesh Bollam

Reasons for mucormycosis in Covid-19
May 21, 2021
Dr. Rajesh Bollam
Microcytic and Hypochromic anemia is one of the common scenario we encounter in Clinics
May 21, 2021
Dr. Rajesh Bollam

Updated Recommendations for Breast Cancer Surveillance in Young Female Cancer Survivors
May 21, 2021
Dr. Rajesh Bollam

Risk Factors of Lung Cancer
Apr 06, 2021
Dr. Rajesh Bollam

Diagnosing lung cancer
Apr 06, 2021
Dr. Rajesh Bollam

Lung cancer and life expectancy
Apr 06, 2021
Dr. Rajesh Bollam

Home remedies for lung cancer symptoms
Apr 06, 2021
Dr. Rajesh Bollam

Facts and statistics about lung cancer
Apr 06, 2021
Dr. Rajesh Bollam

Diet recommendations for people with lung cancer
Apr 06, 2021
Dr. Rajesh Bollam

Lung cancer and smoking
Apr 06, 2021
Dr. Rajesh Bollam

Causes of Lung Cancer
Apr 06, 2021
Dr. Rajesh Bollam

Different Types of Lung Cancer
Apr 06, 2021
Dr. Rajesh Bollam

Stages of LUNG CANCER
Apr 06, 2021
Dr. Rajesh Bollam

Lung Cancer and Lung Cancer Screening
Apr 06, 2021
Dr. Rajesh Bollam

What are the symptoms of lung cancer
Apr 06, 2021
Dr. Rajesh Bollam

Lung cancer occurs when cells divide in the lungs uncontrollably.
Apr 06, 2021
Dr. Rajesh Bollam

KEYNOTE-365
Mar 12, 2021
Dr. Rajesh Bollam

Antiphospholipid syndrome in Pregnancy
Mar 12, 2021
Dr. Rajesh Bollam

Leucocytosis
Mar 12, 2021
Dr. Rajesh Bollam

Patients with liver disease often have blood results that give an appearance of a significant bleeding risk
Mar 12, 2021
Dr. Rajesh Bollam

Navigating Uncertain Times in Muscle-Invasive and Advanced Bladder Cancer
Mar 12, 2021
Dr. Rajesh Bollam

Lenvatinib plus pembrolizumab
Mar 12, 2021
Dr. Rajesh Bollam

From bench to bedside, another practice-changing treatment is on the road!
Mar 12, 2021
Dr. Rajesh Bollam

ASH_hematology VTE guidelines in patients with cancer
Mar 12, 2021
Dr. Rajesh Bollam

How I Rx Newly Diagnosed Mantle Cell Lymphoma
Mar 12, 2021
Dr. Rajesh Bollam

Ipilumumab plus pembrolizumab vs pembrolizumab alone in pdL1 more than 50 percentage Which is better
Mar 12, 2021
Dr. Rajesh Bollam

APML is medical emergency
Mar 11, 2021
Dr. Rajesh Bollam

aHUS is a disease of excessive activation of the alternative complement pathway (ACP)
Mar 11, 2021
Dr. Rajesh Bollam

imp. point to reiterate
Mar 11, 2021
Dr. Rajesh Bollam

Understand B12 Absorption to Learn B12 Def
Mar 11, 2021
Dr. Rajesh Bollam

Indications for auto-transplant - for the oncology fellows
Mar 09, 2021
Dr. Rajesh Bollam

Allogeneic bone marrow transplant is the curative treatment for few relapsed leukemias and Lymphoma
Mar 09, 2021
Dr. Rajesh Bollam

Allo BMT Basics
Mar 09, 2021
Dr. Rajesh Bollam

Myeloid HemePath Pearls
Mar 09, 2021
Dr. Rajesh Bollam
Myeloid HemePath Pearls
Mar 09, 2021
Dr. Rajesh Bollam

Amyloidosis month
Mar 03, 2021
Dr. Rajesh Bollam

Full publication of randomized Scandinavian dose escalation trial for LS SCLC
Mar 03, 2021
Dr. Rajesh Bollam

Hemophilia
Mar 03, 2021
Dr. Rajesh Bollam

Rituximab Maintenance for Follicular lymphoma
Mar 03, 2021
Dr. Rajesh Bollam

PANCYTOPENIA
Feb 23, 2021
Dr. Rajesh Bollam

WHAT IS THE MAIN CAUSE OF LYMPHOMA?
Feb 18, 2021
Dr. Rajesh Bollam
Add a comment